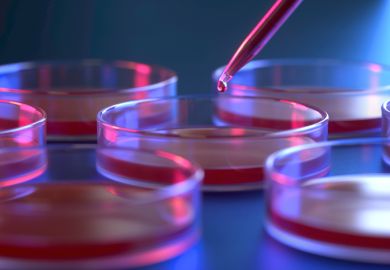

From the beginning of the Covid-19 pandemic, my expertise on emerging viruses has been sought by the media. Sometimes I will be quoted in an article, but I often avoid taking sides on issues that I believe are unresolved, so my statements don’t always make good copy. Still, I frequently recognise my input in the general background statements made by journalists.
I don’t mind not being cited. I regard informing the public as an essential role for a scientist: it is a proviso in the contract we sign that delineates support for our research. And it is particularly important now, given the avalanche of misinformation and conspiracy theories that have shaped public attitudes to the pandemic, pushed by those with anti-science or antisocial agendas.
With that in mind, I also contact journalists who appear to be sincerely interested in conveying authentic information but have been misled by poor sources or plausible but wrong reasoning. After a general expression of appreciation, I normally quote the inaccurate sentences in their articles and explain the flaws with, when appropriate, citations to the scientific literature. When possible, I provide an alternative text.
Most of the time the journalists are quite grateful and are willing to make changes necessary to improve accuracy. My proposed substitute paragraph has sometimes even replaced the defective information completely. Again, I am practically never cited as the source, but I am rewarded through the improvement of the information that the public receives. It does strike me that I might be considered a “ghostwriter”, an occupation that I have condemned in the context of the medical and scientific literature, but even this article will be altered by a highly skilled editor whose authorial input will be largely anonymous, so I don’t trouble myself too much.
Sometimes, however, the journalist will respond with hostility. I know the pressures under which members of the media are operating and I understand why they might assume that anyone questioning their reporting is yet another conspiracy theorist. Sometimes, but not always, I can overcome their initial resistance to dialogue by assuring them that my only motivation is to ensure that accurate science is being conveyed to the public.
Exacerbating that problem is the seeming inability of authorities to convey correct, straightforward and consistent messages. But to some extent that is understandable: complex scientific issues are frequently difficult to render in language that is both simple and true.
As a case in point, my attention was recently directed to a fact-checking post addressing a social-media meme declaring that viruses tend to evolve so that they become less harmful (virulent) to their hosts over time. It appears that the purpose of the meme’s dissemination was to minimise the seriousness of the emergence of Sars-CoV-2 variants. The post, however, was clearly a gross oversimplification in the context of the current pandemic.
If you want to determine whether a photograph represents what it purports to be or whether someone actually made some particular statement, there are well-established criteria for investigation. On the topic of a scientific debate, though, there are normally fewer grounds for making a definitive determination. In this case, without offering an adequate definition of “virulent” or “over time”, the fact-checker unabashedly decided to rate the statement that viruses become less virulent over time as “false”.
I contacted the author. I indicated to her that an old news article was not actually evidence for her assertion. I told her that evolving drug resistance does not qualify as an increase in virulence, and that many animals host viruses that have evolved not to harm them. It was also necessary to correct an assertion about the nature of viral spread that used malaria as an example – malaria is not caused by a virus.
My point here is not to argue that virulence doesn’t decrease over time, especially if virulence is defined as propensity to cause severe disease as a phenomenon separate from its transmissibility and if the time interval is long. The point is that the fact-checker lacked the evidence necessary to definitively reject the claim that virulence decreases, and she had misinterpreted other data. I rated her fact-check as “mostly false” and invited her to discuss the matter further.
I received no direct response, however. And while the sentences about malaria were rapidly removed, the article continued to support its position with a quotation from one article that was directly contradicted by a preceding quotation from a reputable source. This should have been sufficient to demonstrate that the topic was one of scientific debate, not reducible to a true or false judgement.
So, yes, I was frustrated. I felt that my efforts had been only minimally successful in this case. But to paraphrase John Stuart Mill’s inaugural rectorial address to the University of St Andrews, “bad articles need nothing more to compass their ends than that good men should look on and do nothing”.
David A. Sanders is an associate professor of biological sciences at Purdue University in Indiana.
Register to continue
Why register?
- Registration is free and only takes a moment
- Once registered, you can read 3 articles a month
- Sign up for our newsletter
Subscribe
Or subscribe for unlimited access to:
- Unlimited access to news, views, insights & reviews
- Digital editions
- Digital access to THE’s university and college rankings analysis
Already registered or a current subscriber?